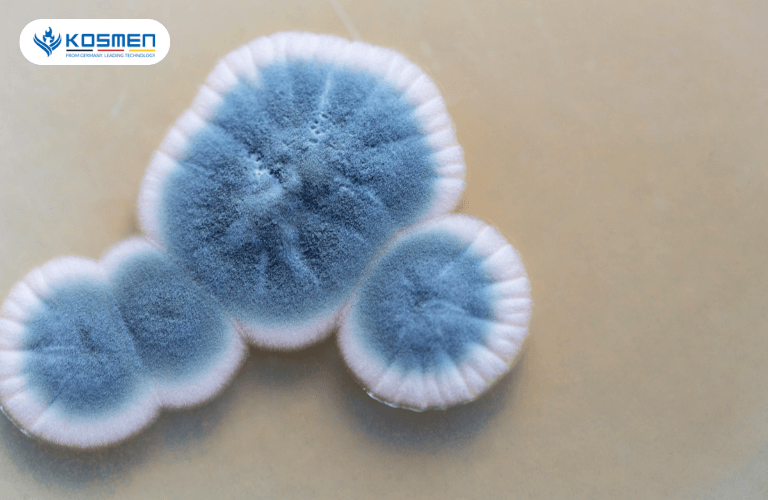

Nấm mốc thường xuất hiện trong ngôi nhà bạn ở nhiều vị trí, ngóc ngách khác nhau. Thế nhưng đừng chủ quan bởi nấm mốc chứa nhiều mối nguy hại mà có thể bạn chưa biết rõ. Cùng Kosmen tìm hiểu tác hại của nấm mốc và ảnh hưởng của nó đến sức khỏe, thực phẩm và cả chất lượng đồ dùng, thẩm mỹ nội thất nhé!
Nấm mốc là gì? Nấm mốc phát triển trong điều kiện nào?
Nấm mốc là một dạng nấm được mọc theo dạng sợi nhỏ đa bào hay còn được gọi là sợi nấm. Chúng thường mọc ở môi trường ẩm ướt, thiếu ánh sáng, ít thông thoáng như trong máy giặt, nhà bếp, nhà tắm...
Chúng còn có rất nhiều màu sắc khác nhau như nấm mốc đen, nấm mốc trắng, nấm mốc xanh, nấm mốc màu cam,... Vi khuẩn nấm mốc là một nhóm đa dạng bao gồm nhiều loại nấm mốc và mỗi loại có điều kiện sinh lý riêng. Tuy nhiên vi khuẩn nấm mốc vẫn thường có một số đặc điểm chung về môi trường sống như nhiệt độ, độ ẩm, ánh sáng, dinh dưỡng,...
Điều kiện để nấm mốc phát triển ở trong khoảng 22-27 độ C kết hợp với môi trường ẩm thấp và không thoáng khí, kém vệ sinh sẽ thuận lợi cho nấm mốc sinh sôi và lan rộng. Ngoài ra, nấm mốc vẫn có thể tồn tại được dưới nhiệt độ 2-5 độ C và lên đến 35-40 độ.

Hình ảnh phóng to của nấm mốc
Phân loại, nhận biết một số loại nấm mốc qua màu sắc
Nấm mốc có hơn 4000 loại khác nhau, rất đa dạng và phong phú về màu sắc, cấu tạo, điều kiện môi trường sống. Dưới đây là phân loại một số loại nấm mốc thường gặp trong đời sống theo màu sắc:
Nấm mốc đen
-
Nấm mốc đen và có kết cấu nhầy nhụa có thể là mốc Stachybotrys, loại mốc này thường xuất hiện ở trên các vật liệu gỗ, bìa cứng, giấy. Chúng có thể gây ra khó thở, mệt mỏi, nhức đầu thậm chí trầm cảm.
-
Một loại nấm mốc đen khác là Ulocladium, chúng thường xuất hiện ở khu vực có nhiều hơi nước ngưng tụ nhiều như phòng tắm, bếp, tầng hầm,... Khi tiếp xúc trực tiếp với các loại nấm mốc này có thể gây ảnh hưởng tới sức khỏe.

Nấm mốc đen bám trên tường
Nấm mốc trắng
-
Nếu ban đầu nấm mốc có màu trắng và chuyển dần sang xám thì đó có thể là loại nấm Chaetomium. Loại nấm này thường xuất hiện trên các bức tường thạch cao và có mùi ẩm mốc gây khó chịu.
-
Nấm mốc Aspergillus cũng thường có màu trắng nhưng cũng có thể có nhiều màu sắc khác. Loại nấm mốc này vô cùng nguy hiểm đến sức khỏe của con người như dẫn đến các cơn hen suyễn, các vấn đề về phổi thậm chí dẫn đến ung thư.

Nấm mốc trắng thường xuất hiện trên thực phẩm, rau củ quả
Nấm mốc xanh
-
Nấm mốc Penicillin có màu xanh lá cây hoặc xanh dương. Thường xuất hiện ở những nơi như ống dẫn nước, dưới thảm hoặc giấy dán tường… Chúng có thể lây lan rất nhanh và gây ảnh hưởng đến sức khỏe.
-
Mốc mọc theo mảng màu xanh là Trichoderma, chúng thường xuất hiện ở những nơi có độ ẩm cao. Nó có thể gây hư hỏng nhà cửa và ảnh hưởng đến sức khỏe con người đặc biệt là tim, gan.
Nấm mốc xanh gây hư hỏng nhà cửa
Nấm mốc màu cam
Loại mốc Aspergillus có màu cam hoặc vàng, xuất hiện ở những nơi có độ ẩm cao và thường xuyên có nước. Loại mốc này dễ gây tác động đến những người có hệ miễn dịch phổi yếu, dễ bị hen, phổi, viêm xoang,...

Nấm mốc màu cam, vàng xuất hiện ở nơi thường xuyên có nước.
Nấm mốc màu nâu
-
Loại nấm mốc có màu nâu có thể là Alternaria, chúng thường xuất hiện ở những nơi ẩm ướt như bồn tắm, bồn rửa, phòng tắm,... Chất độc từ loại nấm này có thể gây hen suyễn.
-
Ngoài ra, loại mốc Aureobasidium cũng có màu nâu và thường có mặt ở bề mặt sơn hay giấy dán tường, nó có thể gây nhiễm trùng da, mắt và móng.

Nấm mốc màu nâu thường có ở những nơi ẩm ướt như phòng tắm
Tác hại của nấm mốc đến môi trường và sức khỏe
Nấm mốc rất dễ hình thành và xuất hiện trong không gian sống nếu độ ẩm trong không khí cao và không khí ít thông thoáng, thiếu ánh sáng mặt trời. Hơn nữa nấm mốc rất dễ phát triển và lan rộng ra nhiều khu vực khác nhau trong nhà. Điều này rất nguy hiểm nếu vô tình đó là loại nấm mốc mang độc tố. Nấm mốc ảnh hưởng khá nhiều đến đời sống con người như sức khỏe, chất lượng đồ dùng, thẩm mỹ nội thất trong nhà,...
Tác hại của nấm mốc đến sức khỏe con người
Nấm mốc sinh sản và lây lan bằng bào tử, nó có thể là một phần của bụi trong nhà. Nếu ở trong môi trường ẩm ướt và lượng nấm mốc nhiều khó tránh khỏi việc hít phải nấm mốc.
Việc hít phải nấm mốc có thể ảnh hưởng đến sức khỏe như cảm thấy uể oải, mệt mỏi, khó chịu, không có hứng thú làm việc. Một số người nhạy cảm khi vô tình tiếp xúc hay hít phải nấm mốc thường có các triệu chứng như nghẹt mũi, thở khò khè, mắt hoặc da bị đỏ, sưng ngứa, hắt hơi, đau đầu, mệt mỏi, đau khớp, nổi mề đay, ho, buồn nôn...
Người già và trẻ nhỏ thường là đối tượng dễ bị nấm mốc tác động mạnh đến sức khỏe do sức đề kháng yếu. Ngoài ra, những người có tiền sử các bệnh về đường hô hấp như hen suyễn thường dễ có phản ứng mạnh hơn khi tiếp xúc với nấm mốc. Dị ứng nấm mốc còn có thể dẫn đến các biến chứng nguy hiểm hơn như: viêm xoang do nấm dị ứng, viêm phổi quá mẫn, dị ứng aspergillosis phế quản phổi….

Nấm mốc ảnh hưởng đến sức khỏe con người. Đặc biệt là người già và trẻ nhỏ.
Quần áo khi xuất hiện nấm mốc mà mắt thường không nhìn thấy được, khi mặc vào khiến ta vô tình tiếp xúc hay hít phải nấm mốc có thể dẫn đến dị ứng hay kích thích một số tình trạng bệnh nguy hiểm hơn. Một số loại nấm mốc còn sản sinh độc tố mycotoxin ảnh hưởng đến sức khỏe con người và động vật. Khi tiếp xúc với nồng độ độc tố mycotoxin cao có thể dẫn đến các vấn đề về thần kinh, thậm chí gây tử vong.
>> Xem thêm:
Một số loại thực phẩm nếu không chú ý bảo quản rất dễ nảy sinh nấm mốc. Nếu chúng ta ăn phải nấm mốc trong thời gian dài sẽ dễ mắc các bệnh nguy hiểm bởi chúng được tích lũy dần, đến một mức độ nào đó sẽ phát bệnh. Một số bệnh nguy hiểm có thể kể đến do nhiễm độc tố nấm mốc trong thời gian dài như: suy thận do ochratoxin, ung thư gan do aflatoxin, ung thư buồng trứng do fumonisins,...
Ngoài ra, nấm mốc khó mà tồn tại được trong môi trường axit cao như dạ dày. Tuy vậy, sau khi ăn phải nấm mốc nên chú ý kỹ đó là tình trạng buồn nôn thông thường hay nghiêm trọng hơn. Nếu tình trạng buồn nôn, ói mửa vẫn kéo dài thì nên đi khám bác sĩ để kịp thời điều trị.
Tác hại của nấm mốc đến thẩm mỹ và chất lượng đồ dùng nội thất
Nấm mốc thường bám vào các vật dụng như tường, giấy dán tường, sàn gỗ, đồ dùng nội thất bằng gỗ,... gây mất thẩm mỹ, khó loại bỏ hoàn toàn nếu nó xuất hiện trong các đường kẻ, ngóc ngách nhỏ. Nếu để lâu còn ảnh hưởng đến chất lượng đồ dùng.
>> Xem thêm:

Nấm mốc làm nội thất trong nhà kém thẩm mỹ.
Những vết nấm mốc dễ gây mất thẩm mỹ, khiến cho căn nhà trở nên cũ kỹ. Nặng nề hơn, chúng còn gây tróc sơn, nứt nẻ, mục tường, mục gỗ nếu không xử lý sớm. Ngoài ra, tủ quần áo, quần áo cũ để lâu ngày không sử dụng đến cũng sẽ xuất hiện nấm mốc, khiến quần áo bị thâm kim, cứng vải, có mùi mốc khó chịu.
Các thiết bị điện tử dễ bị nấm mốc bám vào phát triển bên trong và phá hỏng các vi mạch. Chất lượng các thiết bị không được đảm bảo, hiệu suất không cao, dễ bị gỉ sét. Nguy hiểm hơn còn bị chập mạch, cháy nổ.
Tác hại của nấm mốc đến thực phẩm
Tốc độ nấm mốc lan rộng rất nhanh, chỉ với một đốm nhỏ chúng sẽ phát tán và nhanh chóng xuất hiện ở vị trí khác, không ngừng phát triển và tiếp tục lây lan. Thực phẩm là nơi nấm mốc rất ưa thích, vì hầu hết thực phẩm đều chứa một lượng độ ẩm nhất định. Chỉ cần nấm mốc được phát tán trong không khí thì không lâu sau đồ ăn sẽ sinh nấm mốc và hư hỏng ngay.

Vô tình ăn phải thực phẩm nấm mốc gây tác hại đến sức khỏe.
Ảnh hưởng khi ăn phải nấm mốc bài viết cũng đã đề cập ở phía trên. Tốt nhất bạn không nên ăn thực phẩm đã bị mốc. Cũng không nên cắt bỏ phần mốc đi rồi ăn phần còn lại. Bởi nấm mốc thường xâm nhập trên toàn bộ bề mặt, phần nấm mốc bạn thấy được chỉ là những phần mà nấm mốc nảy mầm thôi.
Qua đó có thể thấy tác hại của nấm mốc không chỉ tác động đến sức khỏe, nội thất, đồ dùng trong nhà. Ngoài ra, thực phẩm cũng là đối tượng dễ bị thực phẩm tấn công. Để hạn chế được những ảnh hưởng của nấm mốc đến sức khỏe nên có những cách diệt nấm mốc hiệu quả và những biện pháp phòng chóng nấm mốc tác động đến sức khỏe và đời sống.
>> Xem thêm: 7 Cách Diệt Và Xử Lý Tẩy Sạch Nấm Mốc Trong Nhà Hiệu Quả
Hy vọng bài viết đã giải đáp thắc mắc về tác hại của nấm mốc và ảnh hưởng của nấm mốc đến sức khỏe. Qua đó, mọi người hãy chú ý các biện pháp phòng ngừa nấm mốc để bản thân và gia đình luôn khỏe mạnh. Nếu mọi người có thắc mắc về máy hút ẩm không khí, liên hệ ngay với Kosmen để được giải đáp một cách nhanh chóng và chu đáo.
Có thể bạn quan tâm:
Có Nên Mua Máy Hút Ẩm Không? Cách Chọn Máy Hút Ẩm Tốt Nhất?
Đẩy Lùi Mùi Ẩm Mốc Khó Chịu Với Máy Hút Ẩm Không Khí Kosmen
Tổng Hợp 5 Máy Hút Ẩm Không Khí Giá Rẻ Bán Chạy 2025
Ngày đăng: 09/09/2022 - Cập nhật ngày: 06/03/2025, lúc: 02:04










_2.png)


